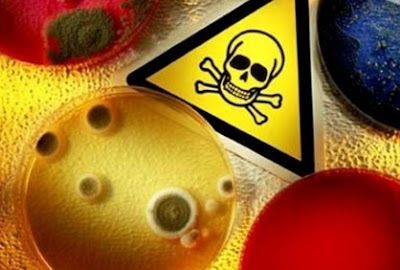

Sering kali KH Gus Ali Masyhuri mengutip pepatah
"Jadikanlah makananmu sebagai obat
dan jangan jadikan obat sebagai makananmu".
Pepatah itu merupakan kutipan dari kata-kata yang sering diucapkan oleh Hippocrates.
Hippocrates adalah seorang dokter yang hidup di jaman Yunani kuno dan sering disebut
sebagai Bapak Kedokteran oleh dunia Barat.
 |
| Manfaat Bawang Putih untuk kesehatan telah diakui oleh dunia kesehatan modern |
Maka sungguh tepat istilah tersebut disematkan pada bawang putih karena bawang putih menyimpan manfaat
untuk kesehatan yang sangat luar biasa. Maka
tak salah apabila para pakar herbal diluar
negeri sangat mengagumi dan menganggap bawang putih sebagai makanan super yang merupakan anugerah
Tuhan bagi umat manusia.
Keajaiban Manfaat Bawang Putih Untuk Kesehatan Hasil Penelitian Modern
Saat ini ilmu pengetahuan modern telah mengenal dan
mengkonfirmasi manfaat bawang putih untuk kesehatan. Bawang putih yang sering
kita gunakan secara tradisional untuk bumbu masakan sehari - hari. Tapi siapa
yang menyangka bawang putih merupakan salah satu makanan yang sangat
menyehatkan.
Berikut ini adalah 13 manfaat bawang putih untuk kesehatan
kita menurut hasil berbagai penelitian
1. Bawang putih mengandung senyawa Allicin yang berpotensi untuk berbagai pengobatan.
Bawang putih adalah
tanaman keluarga bawang. Tumbuh diberbagai belahan bumi dan sangat populer sebagai bahan
masakan karena rasanya yang nikmat dan baunya yang kuat. Namun, menurut sejarah
kuno manusia, bawang putih telah lama digunakan untuk terapi kesehatan.
 |
| Senyawa Allicin dalam bawang putih |
Manfaat bawang putih untuk kesehatan telah lama dikenal oleh
peradaban besar manusia termasuk
peradaban Mesir, Babilonia, Yunani, Romawi
dan Cina. Sekarang kita telah mengetahui bahwa manfaat bawang putih bersumber dari senyawa Allicin.
Senyawa Allicin
diperoleh apabila bawang putih dicincang, ditumbuk atau dikunyah. Allicin di dalam bawang putih masuk
ke dalam tubuh dari saluran pencernaan
dan ke seluruh tubuh dan memberi manfaat kesehatan untuk kita.
2. Bawang putih sangat bernutrisi dan sedikit kalori.
Di dalam bawang putih mengandung berbagai nuitrsi sebagai berikut
:
Mangan, Vitamin B6, Vitamin C, Selenium, dan Serat.
Selain itu jgua terdapat Kalsium, Kalium, Tembaga,
Potassium, Fosfor, Zat Besi dan Vitamin B1
Dalam 28 gram bawang putih mengandung nutrisi berikut ini :
Manganese : 23%
Vitamin B6 : 15%
Selenium : 6%
Vitamin C : 15%
Serat : 6%
Karena kaya manganese, bawang putih sanagat baik untuk
kesehatan kardiovaskular. Manganese adalah mineral yang diperlukan oleh otot
termasuk otot jantung.
3. Bawang Putih dapat melawan penyakit, termasuk flu
Suplemen bawang putih dikenal atas fungsinya untuk sistem
ketahanan tubuh. Sebuah studi selama 12 minggu menemukan bahwa mengkonsumsi
bawang putih dapat menurunkkan flu 63% dibanding menggunakan placebo.
Rata - rata gejala flu juga berkurang selama 70%. Orang yang
mengkonsumsi bawang putih akan mengalami gejala flu selama 1.5 hari, sedangkan
orang yang tidak mengkonsumsi bawang putih mengalami gejala flu selama 5 hari.
Sedangkan hasil studi lain menyebutkan bahwa mengkonsumsi
bawang putih dapat bermanfaat menurunkan lama sakit flu hingga 61%
Jika anda sering terkena flu atau sedang terkena flu, maka
menambahkan bawang putih ke dalam makanan anda sehari - hari akan sangat
membantu mempercepat penyembuhan flu.
4. Senyawa aktif bawang putih dapat menurunkan tekanan darah
Penyakit Kardiovaskular seperti serangan jantung dan stroke
adalah pembunuh terbanyak di dunia. Hipertensi atau tekanan darah tinggi adalah
salah satu penyebab dari kedua penyakit tersebut.
 |
| Mengkonsumsi bawang putih secara rutin dapat menurunkan tekanan darah tinggi |
Penelitian telah mempelajari bahwa mengkonsumsi bawang
putih dapat menurunkan tekanan darah
pada para penderita penyakit darah tinggi.
Dalam sebuah studi, ekstrak bawang putih sebanyak 600 s/d
1500 mg sama efektifnya dengan Atenolol dalam menurunkan tekanan darah tinggi. Dosis
mengkonsumsi bawang putih harus cukup tinggi untuk mendapatkan hasil yang
diharapkan.
5. Bawang putih memperbaiki level Kolesterol yang juga dapat menurunkan resiko penyakit jantung.
 |
| Manfaat Bawang Putih untuk menurunkan resiko penyakit jantung |
Kandungan sulfur dalam bawang putih (polysulfida) digunakan
oleh sel darah merah untuk menghasilkan H2S. H2S inilah yang dapat membantu
pembuluh darah menjadi lebih lebar/melebar. Sementara itu beberapa ekstrak
bawang putih yang telah diproses tidak memberi dampak seperti diatas.
Hal itu terjadi karena Allicin dalam ekstrak bawang putih
hanya bertahan dalam 2 sampai 16 jam saja. Sementara Allicin yang diperoleh
dari bawang putih mentah yang ditumbuk akan bertahan hingga 2 hari.
6. Antioksidan di dalam Bawang putih bermanfaat untuk mencegah Penyakit Alzheimer dan Demensia
Kerusakan oksidasi karena radikal bebas berkontribusi atas
proses penuaan. Sedangkan Bawang putih memiliki kandungan antioksidan yang
mendukung tubuh untuk melindungi diri dari kerusakan akibat oksidasi.
 |
| Mengkonsumsi bawang putih secara teratur dapat mencegah Alzheimer |
Suplemen bawang putih dalam dosis tinggi telah menunjukkan
peningkatan enzym antioksidan dalam tubuh manusia. Dengan kemampuan mencegah
oksidasi akibat radikal bebas serta kemampuan menurunkan tekanan darah inggi
dapat mencegah otak dari serangan Alzheimer dan Demensia.
Dengan kata lain, antioksidan dalam bawang putih dapat
melindungi sel-sel dari kerusakan dan penuaan. Termasuk sel-sel otak dan hal
tersebut dapat mencegah penyakit Alzheimer dan Demensia
Demensia adalah kondisi dimana otak mengalami kemunduran. Hal
ini disebabkan adanya kerusakan pada sel-sel otak. Gejala gejala demensia
adalah sering lupa (memori jangka pendek mengalami penurunan), adanya perubahan
kepribadian, dan emosi yang naik turun dan mudah marah secara tiba - tiba. Bentuk umum dari Demensia adalah
Alzheimer.
Penyakit Alzheimer adalah kondisi sel - sel otak mati dan
volume otak mengecil dan sinyal-sinyal otak sulit tersalurkan dengan baik.
Alzheimer sering dikaitkan sebagai penyakit orang tua. Resiko mengalami
Alzheimer meningkat seiring dengan bertambahnya usia.
7. Bawang Putih dapat memperpanjang umur.
Sebagaimana dijelaskan pada keterangan diatas, bahwa manfaat
bawang putih adalah menurunkan kolesterol total, menurunkan trigliserida,
menurunkan tekanan darah tinggi, sebagai antioksidan sehingga dapat menurunkan
resiko kanker. Maka secara tidak langsung bawang putih bermanfaat untuk
menurunkan resiko penyakit jantung, penyakit stroke dan kanker.
 |
| Serangan jantung |
Selain itu bawang putih bermanfaat sebagai antiinfeksi
sehingga dapat melawan penyakit yang disebabkan oleh infeksi. Di seluruh dunia, dari data tahun 2012 di ketahui bahwa orang meninggal dunia akibat penyakit koroner
sebanyak 7.5 juta orang dan akibat serangan stroke sebanyak 1.2 juta orang .
8. Bawang putih bermanfaat meningkatkan performa jantung
Bawang putih telah digunakan semenjak ratusan tahun yang
lalu pada Olimpiade atletik di Yunani kuno. Bawang putih pada saat itu
digunakan untuk meningkatkan kemampuan para atlit. Penelitian modern
menyebutkan bahwa bawang putih dapat digunakan untuk meningkatkan kemampuan
jantung terutama bagi orang - orang yang memiliki masalah pada jantung seperti
penderit jantung lemah.
9. Bawang putih bermanfaat untuk membuang racun logam berat dari tubuh
Pada dosis yang
tinggi, senyawa belerang di dalam bawang putih mampu melindungi organ tubuh
dari kerusakan akibat racun logam berat.
Dalam sebuah penelitian yang berlangsung selama 4 minggu,
para pekerja di pabrik baterai mobil mengalami penurunan kadar racun dalam
tubuh sebanyak 19% setelah mengkonsumsi bawang putih. Termasuk sakit kepala dan
tekanan darah tinggi.
Dosis 3 siung bawang putih telah menunjukkan performa
memuaskan dan melampaui obat - obatan kimia dalam mengurangi keracunan.
10. Manfaat bawang putih untuk kesehatan tulang
Pada penelitian terhadap tikus menunjukkan bahwa konsumsi
bawang putih pada tikus betina memberi dampak peningkatan estrogen. Sedangkan
tingkat peluruhan tulang mengalami penurunan.
Pada satu penelitian pada perempuan menopause, pemberian
bawang putih berdampak menghambat defisiensi estrogen. Hal ini menunjukkan
bahwa bawang putih bermanfaat untuk kesehatan tulang khususnya wanita menopause
dengan memperlambat proses pengapuran tulang.
Makanan seperti bawang putih dan bawang jga memberikan
dampak positif pada osteoarthritis karena memiliki kandungan antioksidan
sehingga menghambat osteoarthritis.
Osteoartritis adalah penyakit dimana sendi terasa sakit dan
nyeri karena inflamasi ringan. Inflamasi ringan ini timbul karena karena
gesekan pada ujung-ujung tulang penyusun sendi. Oleh dunia kedokteran
Osteoarthritis sering disingkat OA.
11. Untuk mengobati jerawat dan kecantikan wajah
Jerawat dan bekas luka dapat disembuhkan dengan menggunakan
bawang putih. Kita ketahui bahwa bawang putih mengandung antibakteri dan
antiinfeksi. Dengan mengoleskan bawang putih yang telah ditumbuk akan dapat
mengobati jerawat. Biarkan selama 10 menit kemudian bilas dengan air.
Bawang putih juga bermanfaat untuk membersihkan kulit yang
berkomedo. Untuk bagian wajah yang berkomedo, oleskan bawang putih yang telah
ditumbuk dan diamkan selama beberapa saat. Kemudian bersihkan dengan air
bersih. Anda akan mendapat wajah yang lebih bersih dan segar.
12. Bawang putih dapat mengobati sakit gigi.
Apabila anda memiliki gigi yang berlubang dan terasa sakit,
cobalah menggigit bawang putih yang sudah ditumbuk pada gigi yang terasa sakit.
Sifat antibakteri pada bawang putih akan membunuh bakteri yang membuat gigi
anda sakit.
13. Bawang putih menjadi penyedap masakan
Salah satu manfaat bawang putih walaupun tidak
terhubung langsung dengan kesehatan
adalah bawang putih menjadi salah satu
bahan utama dalam setiap resep masakan. Hampir setiap masakan kita selalu
menggunakan bawang putih dan hal tersebut menjadikan masakan menjadi lebih
nikmat.
Tetapi perlu diingat bahwa senyawa aktif Allicin hanya akan
dihasilkan oleh bawang putih ketika dihancurkan atau diiris tipis - tipis. Jika
dimasak terlebih dahulu (direbus atau digoreng) kemudian dimasak, tidak
menghasilkan manfaat yang sama.
Oleh karena itu, untuk mendapatkan manfaat Allicin dalam
bawang putih adalah memakan nya dalam kondisi mentah atau, ditumbuk /
dihancurkan atau diiris tipis - tipis dan biarkan sejenak. Setelah beberapa
saat tambahkan bawang putih tersebut ke dalam resep anda.
Penyajian bawang putih untuk pengobatan
Sekali lagi, Untuk mendapatkan Allicin secara optimal maka
bawang putih mentah ditumbuk atau diiris kecil-kecil kemudian diamkan beberapa
saat. Setelah itu bawang putih boleh ditumis, atau dicampur dengan bahan yang
lain. Salah satu resep yang sangat bagus adalah kombinasi bawang putih dengan
minyak zaitun.
Efek Samping
Bawang putih yang dikonsumsi secara mentah akan terasa cukup
panas di lambung, apabila anda konsumsi dalam jumlah cukup banyak mungkin akan
membuat perut anda sakit. Sebaiknya konsultasikan pada dokter apabila anda ingin
mengkonsumsi bawang putih mentah tetapi memiliki masalah dengan pencernaan dan
lambung .
Cara Menyajikan dan Memasak Bawang Putih agar manfaat bawang putih untuk kesehatan dapat diperoleh secara maksimal
Untuk mendapatkan manfaat bawang putih secara optimal,
siapkan 1 siung bawang putih pada resep makanan untuk setiap 1 porsi. Hal itu
berarti bila anda memasak sayur untuk 8 porsi ,siapkan 8 siung bawang putih
untuk sekali masak.
Cara memasak paling sehat agar diperoleh manfaat bawang
putih untuk kesehatan secara optmal adalah dengan mengiris kecil-kecil atau
dengan menumbuk bawang putih, biarkan selama 5 hingga 10 menit. Kemudian
dimasak. Proses memasak cukup selama 5 - 15 menit dengan panas maksimal
mencapai 120'C. Memasak melebihi 177 Celcius. Memasak terlalu lama dan terlalu
panas akan menurunkan manfaat bawang putih. Memasang menggunakan microwave
selama 60 detik saja dapat menghilangkan manfaat bawang putih.
Cara paling optimal adalah dengan menumbuh atau mengiris
bawang putih kecil - kecil, dan biarkan selama 10 menit, maka seluruh manfaat
bawang putih untuk kesehatan akan diperoleh secara optimal, termasuk untuk
melawan kanker. Memasak dengan bumbu bawang putih disarankan tidak diatas
temperatur 120'C dan tidak lebih dari 15 menit.
Demikianlah cara memasang bawang putih dengan benar supaya
kita bisa memperoleh manfaat bawang putih untuk berbagai kondisi kesehatan
secara optimal.

BalasHapusingin mendapatkan uang banyak dengan cara cepat
di f@ns*p0ker || add pin bb 55F97BD0